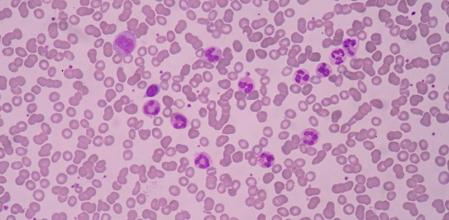
Horizontal

Los leucocitos o glóbulos blancos (neutrófilos, monocitos, eosinófilos, basófilos y linfocitos) son producidos en la médula ósea y tienen la función de combatir virus, gérmenes y bacterias en el sistema sanguíneo. Las personas sanas suelen tener un recuento de 7.500 leucocitos por milímetro cúbico de sangre; sumar más de 11.000 leucocitos por milímetro cúbico de sangre se llama leucocitosis. Esto puede indicar que el organismo requiere más leucocitos en sangre periférica por una infección, por una inflamación por hiperproducción de estas células en la médula ósea. Esto último puede indicar una leucemia.
Causas de la leucocitosis
Producción anormal de leucocitos
Las causas que pueden llevar a la producción anormalmente elevada de leucocitos y, con ello, a una leucocitosis son:
- Una producción elevada de glóbulos blancos para combatir una infección viral o bacteriana.
- Una reacción a un medicamento que aumenta la producción de glóbulos blancos como pueden ser corticoesteroides y/o epinefrina.
- Una enfermedad de la médula ósea, que provoca la producción anormalmente elevada de glóbulos blancos.
- Un trastorno del sistema inmunitario que aumenta la producción de glóbulos blancos como la artritis reumatoide.
Leucocitosis: más de 11.000 leucocitos/milímetro cúbico de sangre.
Los factores de riesgo que pueden llevar a una leucocitosis son:
- Tabaquismo.
- Estrés físico y/o emocional intenso.
- Reacciones alérgicas graves.
Tipos de leucocitosis:
- Leucocitosis neutrófila. Cantidad anormalmente alta de neutrófilos que son los encargados de enfrentar infecciones bacterianas o fúngicas. Mueren después de fagocitar los patógenos. Viven unos cinco días en la sangre circulante y se considera un recuento normal de 3000 a 6000 por milímetro cúbico de sangre.
- Leucocitosis linfocítica. Recuento alto de linfocitos B, T o de células NK (natura killer). Los linfocitos T coordinan la respuesta inmune celular; los linfocitos B producen anticuerpos capaces de unir, bloquear y promover la destrucción de patógenos; las células NK destruyen las células infectadas y contribuyen a la regulación de la respuesta del sistema inmune. El número total normal de linfocitos en sangre es de 1500 a 4000 células por milímetro cúbico.
- Monocitosis. Cantidad elevada de monocitos en sangre. Los monocitos, al igual que los neutrófilos, fagocitan los patógenos pero su supervivencia en la sangre circulante es mayor; además de acabar convirtiéndose, cuando abandonan el torrente sanguíneo, en macrófagos de tejidos. El recuento normal de monocitos se sitúa entre 200 y 300 células por milímetro cúbico de sangre.
- Eosinofilia o hipereosinofilia. Recuento alto de eosinófilos. Son las células que combaten las infecciones parasitarias. También son las células inflamatorias predominantes durante una reacción alérgica. La eosinofilia suele estar causada por el asma, la rinitis alérgica y las infecciones parasitarias. El recuento normal en sangre es de 120 a 130 células por milímetro cúbico de sangre.
- Basofilia. Cantidad elevada de basófilos, por encima de 40 células por milímetro cúbico de sangre. Puede ser el resultado de reacciones alérgicas o infecciones. Los basófilos liberan histamina como respuesta a las alergias lo que produce vasodilatación. La basofilia también puede estar causada por un trastorno autoinmune como el hipotiroidismo.
Síntomas de la leucocitosis
Malestar general, dificultad para pensar y otros síntomas
Los síntomas o signos que produce un recuento alto de leucocitos en sangre son:
- Fiebre y/o escalofríos
- Sangrado.
- Aparición de hematomas en la piel.
- Debilidad y/o cansancio.
- Malestar general.
- Sudoración excesiva.
- Dolor u hormigueo en sus brazos, piernas, o abdomen
- Dificultad para respirar.
- Dificultad para pensar.
- Problemas visuales.
- Pérdida involuntaria de peso o pérdida de apetito.
Diagnóstico de la leucocitosis
Análisis de sangre y biopsia de la médula ósea
Un análisis de sangre muestra el recuento alto de leucocitos. La identificación del tipo de leucocitos que provocan la leucocitosis se podrá determinar obteniendo, mediante biopsia, una muestra de la médula espinal.
Tratamiento y medicación de la leucocitosis
Líquidos vía intravenosa
El tratamiento depende de la causa de la leucocitosis. La pauta que dicte el hematólogo puede ser administrar líquidos vía intravenosa en el hospital; antibióticos frente a las infecciones bacterianas; antiinflamatorios para disminuir la inflamación o tratar infecciones. En caso de leucemia, como la leucemia crónica se administran quimioterapia y medicamentos dirigidos.
Otro posible tratamiento es la leucoféresis, un procedimiento para disminuir el número de glóbulos blancos extrayendo la sangre utilizando una cánula intravenosa. Se extrae muestra para el laboratorio y los glóbulos blancos son separados para volver a inyectar la sangre en el cuerpo.
Prevención de la leucocitosis
Hábitos saludables
Los hábitos saludables son la mejor medida de prevención frente a la leucocitosis, además de evitar contraer parásitos e infecciones virales, bacterianas o fúngicas. Se trata de favorecer el metabolismo de nuestro organismo llevando un estilo de vida saludable, evitando el estrés, siguiendo una dieta sana y equilibrada, cuidando la higiene personal y descansando, al menos, con un sueño reparador, unas siete horas al día.
Este artículo fue publicado el 1 de julio de 2019